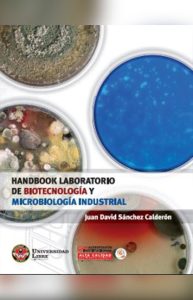

Sistema Nacional de Bibliotecas de la Universidad Libre
Descubre todo lo que nuestras bibliotecas tienen para ofrecer, desde una amplia colección de recursos hasta una variada oferta de servicios que tenemos para ti.
Utiliza el buscador para encontrar los contenidos que necesitas
Bibliotecas por Seccional
Vive la experiencia del SIBUL a través de nuestras Bibliotecas ubicadas en:
Novedades en Acceso Abierto
Noticias
Mantente actualizado sobre todo lo que sucede en Unilibre.

Descubre herramientas clave del CRAI – Biblioteca para potenciar tu aprendizaje, investigación y procesos académicos

Biblioteca Gerardo Molina ajusta sus horarios durante el periodo intersemestral 2026

Aprovecha las capacitaciones de la Biblioteca

IX Feria de Servicios de la Biblioteca
Eventos
Ver más eventosPreguntas frecuentes
¿Cómo adquieres el material bibliográfico en SIBUL?
El material bibliográfico físico lo adquieres por solicitud de las diferentes facultades a las bibliotecas que hacen parte de SIBUL., dicho proceso se realiza acorde a los procedimientos establecidos en nuestro Sistema de Gestión de Calidad. Para mayor información escríbenos a:
Bogotá: biblioteca.bog@unilibre.edu.co o también a johanna.florez@unilibre.edu.co
Barranquilla: adolfo.estrada@unilibre.edu.co
Cali: holman.mendoza@unilibre.edu.co
Pereira: adriana.oyuela@unilibre.edu.co
Cúcuta: clara.cortes@unilibre.edu.co
Socorro: david.arango@unilibre.edu.co
Cartagena: Karen.paez@unilibre.edu.co
¿Cómo consulto mi estado de cuenta o si tengo algún pendiente con mi biblioteca?
- Ingresa a la página de la SIBUL https://www.unilibre.edu.co/biblioteca/
- Haz clic en tu biblioteca seccional
- Ubica la sección de “renovación en línea” o “mi estado de cuenta”.
- Ingresa tu usuario y contraseña (si no la recuerdas, pregunta en el área de Circulación y Préstamo)
- Una vez hayas ingresado te aparecerá el material en préstamo o aquel material que se encuentra en mora. Para saber el valor de la sanción monetaria debes devolver el libro para que en tu estado de cuenta aparezca el valor a cancelar.
Para mayor información, escríbenos a
Bogotá: biblioteca.bog@unilibre.edu.co | nidian.buitrago@unilibre.edu.co
Barranquilla: reinaldo.reales@unilibre.edu.co
Cali: alba.zuniga@unilibre.edu.com | nathalia.sabogal@unilibre.edu.co
Pereira: biblioteca.pei@unilibre.edu.co
Cúcuta: clara.cortes@unilibre.edu.co
Socorro: david.arango@unilibre.edu.co
Cartagena: Karen.paez@unilibre.edu.co
¿Cómo puedes acceder a los recursos virtuales de la biblioteca?
- Ingresa al portal de la Biblioteca Seccional.
- Haz clic en la opción “Bases de Datos”
- Elije la base de datos a consultar.
- Ingresa el usuario y contraseña del sistema académico.
¿Cómo puedes acceder a los recursos virtuales de la biblioteca?
- Ingresa al portal de la Biblioteca Seccional.
- Haz clic en la opción “Bases de Datos”
- Elije la base de datos a consultar.
- Ingresa el usuario y contraseña del sistema académico.